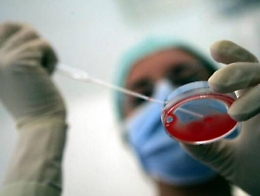
Fecondazione assistita: il Cannizaro presto centro di crioconservazione

17 dicembre 2025
- Aggiornato alle 13:50
Tutte le notizie aggiornate su crioconservazione
Tutte le notizie su crioconservazione aggiornate in tempo reale dalla redazione
Risultati:crioconservazione
Trovati 2
Ordina per:
Copyright © 2025 • La Sicilia Investimenti S.p.A. • P.I. 03133580872 • All rights reserved• Powered by GMDE srl







-1761147112036.png)